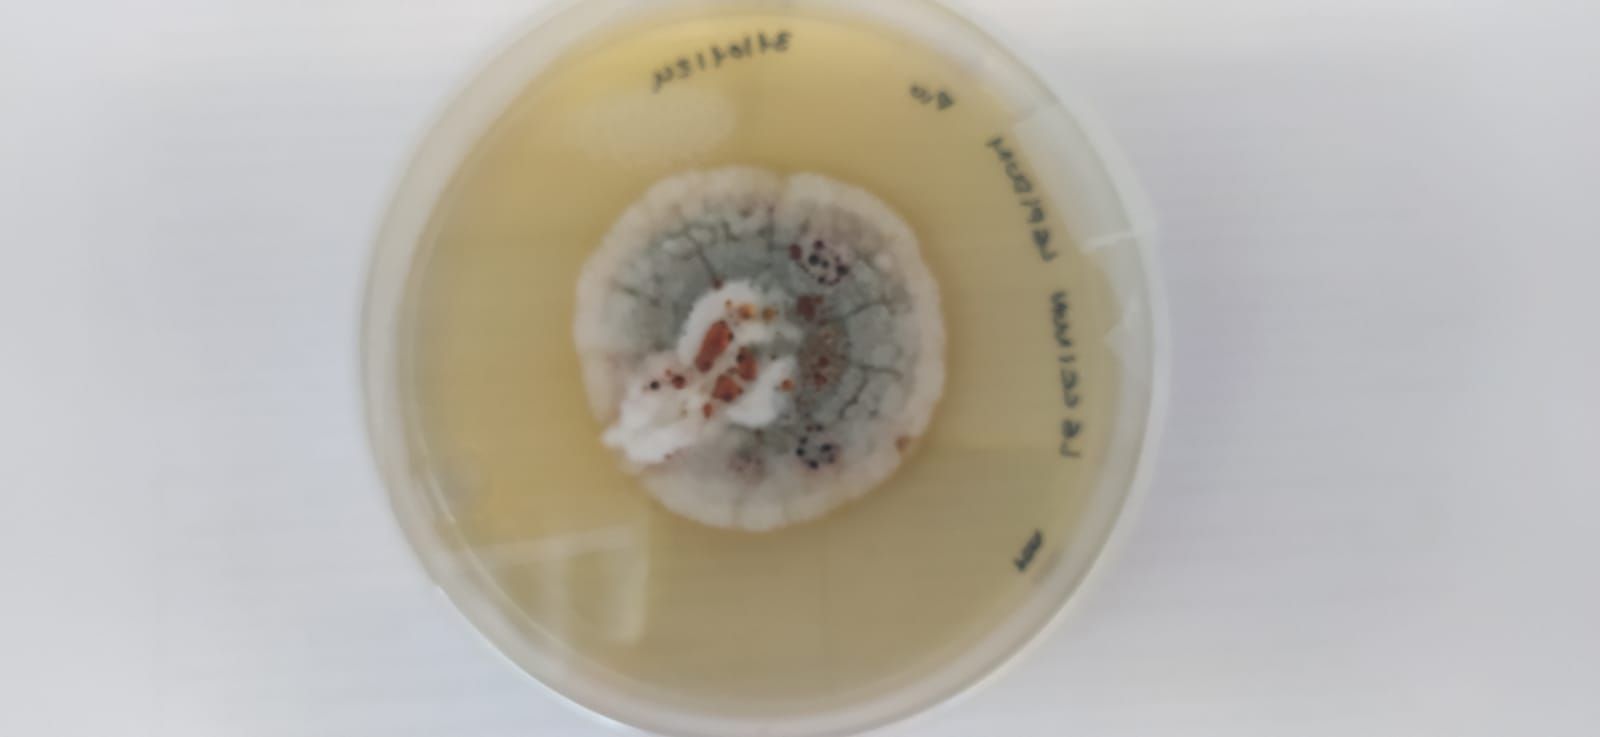
Imagen del estudio

Las setas de Zamora, al servicio de la ciencia
Ha conseguido identificar y aislar los principales hongos micorrizógenos
La Diputación de Zamora , a través del Área de Agricultura y Ganadería, colabora con el Instituto de Investigación Agrobiotecnológica de la Universidad de Salamanca (CIALE) en el desarrollo de un proyecto de investigación con el que se pretende constituir una colección de hongos micorrizógenos procedentes del Parque Micológico Montes del Noroeste Zamorano.
El proyecto, desarrollado por el grupo de investigación reconocido que lidera la doctora Mónica Calvo Polanco, ha conseguido identificar y aislar los principales hongos micorrizógenos que aparecen en los distintos hábitats del Parque Micológico con el fin de utilizarlos en investigación y conservar su interesante acervo genético.
La importancia de la investigación radica en las características específicas de estos hongos que permiten, a través de la micorrización con las diferentes especies de plantas, una mejor adaptación de la vegetación al cambio climático y, en definitiva, su supervivencia en condiciones ambientales muy desfavorables.
El Parque Micológico cuenta con especies de alto valor gastronómico como el Boletus edulis de jara, denominado “zamoranito”, muy valorado en los mercados nacionales e internacionales.
Ésta y otras especies, forman parte de los recursos empleados por las numerosas empresas micológicas de la provincia que contribuyen a frenar el avance de la despoblación en las zonas rurales.
También te puede interesar
Lo último








